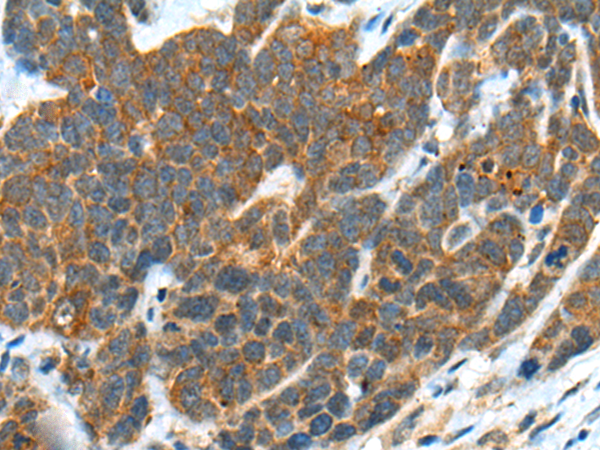

中文名稱:兔抗B3GNT3多克隆抗體
|
Background: |
This gene encodes a member of the beta-1,3-N-acetylglucosaminyltransferase family. This enzyme is a type II transmembrane protein and contains a signal anchor that is not cleaved. It prefers the substrates of lacto-N-tetraose and lacto-N-neotetraose, and is involved in the biosynthesis of poly-N-acetyllactosamine chains and the biosynthesis of the backbone structure of dimeric sialyl Lewis a. It plays dominant roles in L-selectin ligand biosynthesis, lymphocyte homing and lymphocyte trafficking. |
|
Applications: |
ELISA, WB, IHC |
|
Name of antibody: |
B3GNT3 |
|
Immunogen: |
Synthetic peptide of human B3GNT3 |
|
Full name: |
UDP-GlcNAc:betaGal beta-1,3-N-acetylglucosaminyltransferase 3 |
|
Synonyms: |
TMEM3; B3GN-T3; B3GNT-3; HP10328; B3GAL-T8; beta3Gn-T3 |
|
SwissProt: |
Q9Y2A9 |
|
ELISA Recommended dilution: |
5000-10000 |
|
IHC positive control: |
Human colorectal cancer and human thyroid cancer |
|
IHC Recommend dilution: |
25-100 |
|
WB Predicted band size: |
43 kDa |
|
WB Positive control: |
Hela and 293T cell lysates |
|
WB Recommended dilution: |
200-1000 |

購(gòu)物車(chē)
幫助
021-54845833/15800441009
